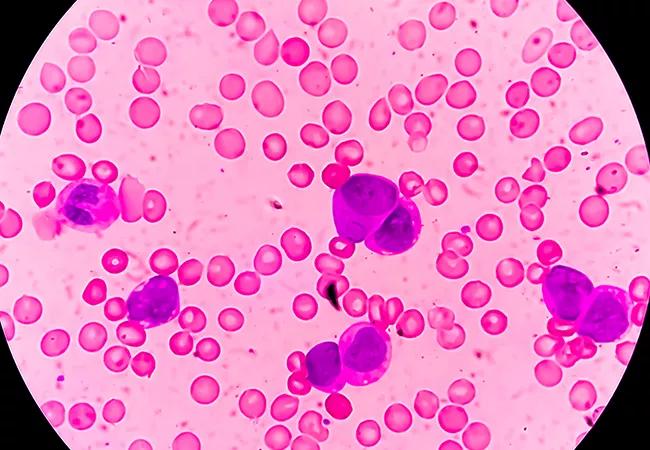

Study finds drug safe and effective when combined with chemotherapy
Image content: This image is available to view online.
View image online (https://assets.clevelandclinic.org/transform/0a35ec36-5e66-450e-93b3-c8287ef3ddd0/21-CNR-2429408-CQD-650x450-1_jpg)
Photomicrograph of Acute Myeloblastic Leukemia (AML), a cancer of white blood cell
The addition of uproleselan to standard chemotherapy regimens appears to reduce the rate of relapse and mucositis in patients with relapsed or refractory (R/R) acute myeloid leukemia (AML). These findings, recently published in the journal Blood, strongly support the initiation of phase III randomized studies to confirm the validity of this approach.
Advertisement
Cleveland Clinic is a non-profit academic medical center. Advertising on our site helps support our mission. We do not endorse non-Cleveland Clinic products or services. Policy
Uproleselan, or GMI-1271, is a novel E-selectin inhibitor that has been shown to disrupt cell survival pathways and enhance chemotherapy response. Researchers initiated a multicenter phase I/II study to evaluate the safety, tolerability, and anti-leukemic activity of the drug (5-20 mg/kg) when combined with chemotherapy in patients with R/R AML.
“Outcomes with standard chemotherapy are typically not as good as we’d like them to be in this patient population, and one of the contributors to poor outcomes is E-selectin–mediated drug resistance,” explains study co-author Anjali Advani, MD, Director of Cleveland Clinic’s Inpatient Leukemia Program at Taussig Cancer Institute. “The encouraging findings from this phase I/II study suggest that uproleselan can be administered safely in conjunction with standard chemotherapy in patients with relapsed or refractory disease.”
In the R/R AML cohort, patients included in both the dose-escalation and expansion phases were at least 18 years of age and showed evidence of active leukemia. Eligible subjects were required to have either primary refractory AML following receipt of one or two prior induction regimens, or be in their first or second relapse.
Study subjects were required to undergo an intensive induction regimen that included mitoxantrone, etoposide and cytarabine. Researchers did allow for prior stem cell transplantation. Eligible patients also had an ECOG performance status of 0-2, with acceptable baseline renal and hepatic function.
Advertisement
The investigators enrolled newly diagnosed patients in a separate cohort. These participants were 60 years or older and candidates for intensive chemotherapy. Aside from hydroxyurea, no prior AML treatment was allowed.
Between May 2015 and May 2017, 91 patients were treated with a combination of uproleselan and chemotherapy. This included 66 patients with R/R AML, 19 of whom were enrolled in the dose-escalation phase, and 47 of whom were enrolled in the expansion phase.
Fifty-four patients received the recommended phase II dose of uproleselan. Among patients in the newly diagnosed AML cohort, 25 were treated with 7+3 in combination with the recommended phase II dose of uproleselan.
Uproleselan, at doses ranging from 5-20 mg/kg, was generally well-tolerated, and no dose-limiting toxicities were noted among the patients enrolled in phase I of the study. The recommended phase II dose was identified as uproleselan 10 mg/kg twice daily. No patients in the R/R AML cohort discontinued treatment due to an adverse event. Any toxicities observed in patients with newly diagnosed disease were exclusively related to the effects of underlying leukemia and the chemotherapy “backbone,” explains Dr. Advani.
At the recommended phase II dose, the remission rate for patients with R/R disease was 41%, and the median overall survival was 8.8 months. The complete response/complete response with incomplete count recovery rate for newly diagnosed patients was 72%, and the median overall survival was 12.6 months.
Advertisement
Another interesting finding, Dr. Advani notes, is the association between the addition of uproleselan and low incidence of oral mucositis (2%), a common and debilitating complications of cancer treatment. “Adding uproleselan to standard MEC therapy appears to significantly reduce the risk of oral mucositis – an important benefit that can improve quality of life,” she adds.
Building on these promising findings, Dr. Advani and her colleagues have opened a randomized phase III trial to further explore uproleselan as a treatment for R/R AML. Researchers will compare standard of care with chemotherapy alone to uproleselan plus chemotherapy. In addition to overall survival, the trial will compare the incidence of severe oral mucositis and overall response rate.
“We hope that our findings will confirm the value of adding uproleselan to salvage chemotherapy and eventually lead to FDA approval of the combination protocol in patients with relapsed or refractory AML if the encouraging results are validated,” concludes Dr. Advani.
Advertisement
Advertisement
Creating a safe space for patients
Long-term immune effects reshape preventative strategies and timelines
Large-scale database also reveals potential for immunotherapy to protect against cancer
Findings may help guide discussions around prognosis and allogeneic stem cell transplantation
Research underscores the importance of access to timely diagnosis and treatment in this patient population.
A Cleveland Clinic model combining clinical staging, genomics and AI predicts survival with 18% greater accuracy — and could help match patients to more effective treatments.
Study serves as ‘cautionary tale’ for physicians tempted to rely on liquid biopsy results alone
Direct delivery of viral-based vector KB707 to the lungs may boost anti-tumor response and help overcome immune checkpoint inhibitor resistance